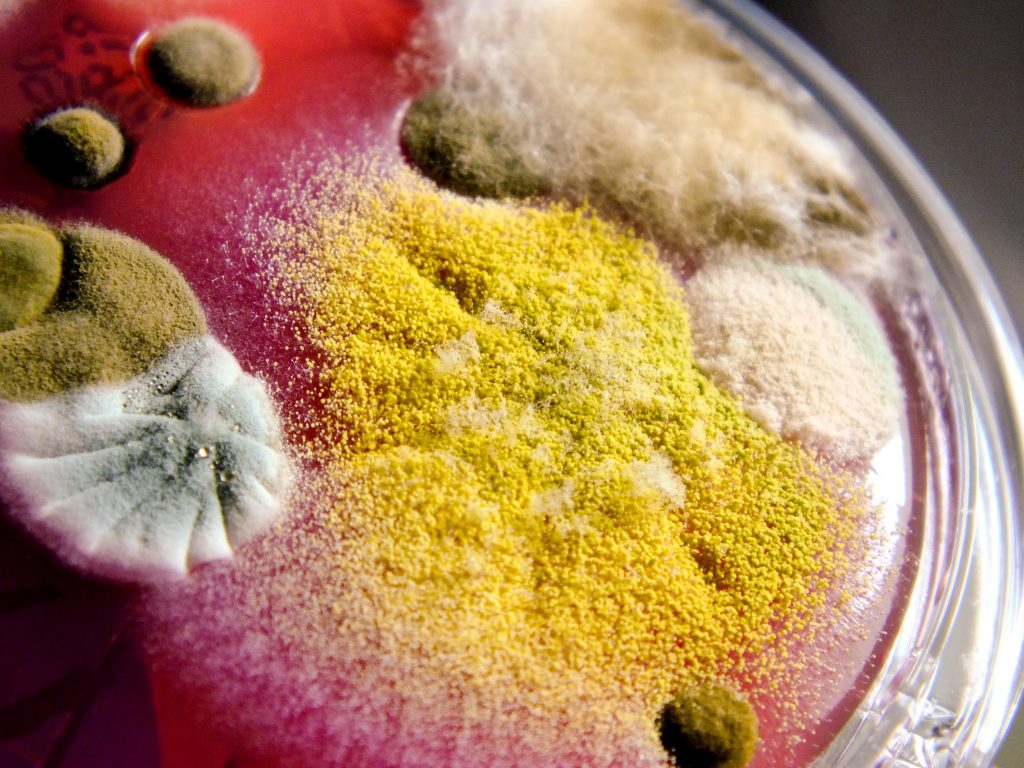

Encuentran hongo capaz de convertirte en Zombie 🧠🧟♂🧟♀
Australia es protagonista de múltiples curiosidades; cuando se trata de animales, siempre logra sorprendernos. En esta ocasión, han encontrado un hongo marino capaz de encoger cerebros con solo tocarlo.

Por supuesto, es venenoso y es tan potente que puede matar a una persona adulta si no recibe antídoto y tratamiento médico a tiempo. Ray Palmer, científico australiano y amante de los hongos, ha dedicado su vida a buscarlos y fotografiarlos. Sin embargo, ha hecho el descubrimiento de su vida al encontrar a este peculiar hongo.

El hongo que te encoje el cerebro al tocarlo
Se trata de una especie de ‘hongo-coral’, de nombre coral de fuego, que se da con frecuencia en Corea del Sur y Japón, por ello, el hallazgo es sorprendente, pues científicos australianos se preguntan: “¿Qué hace esta especie en Australia?”
Bien, a pesar de ser mundialmente conocido, este hongo sorprende por ser uno de los “corales” más venenosos de los que se tiene conocimiento hasta la fecha.

Asimismo, el descubrimiento se cataloga como extraordinario ya que, el color de este hongo-coral es rojizo y su textura es bastante lisa. También, estudios realizados revelaron que puede matar a una persona adulta, de no ser atendida y si la persona se salva, quedaría con graves consecuencias, como tener fallos respiratorios y hasta el encogimiento de su cerebro.

¡Podrías quedar como Zombie!
Palmer tomó una muestra del ‘sujeto’
Hasta la fecha se desconocen los métodos que Roy utilizó para extraer la muestra, sin embargo, logró tomar una muestra del hongo mientras hacía un recorrido por la selva tropical marina, cercana a la Gran Barrera de Coral. Posteriormente, lo llevó hasta la Universidad James Cook Cairns para analizarlo y confirmar la sospecha de que era un coral de fuego.

Por su parte, Roy declaró que desde que lo vio se dio cuenta de que se trataba de un ejemplar de esta especie y por ello tuvo suficientes precauciones para no resultar envenenado por contacto, debido a que los conoce bastante bien.
Tras el hallazgo, los científicos dijeron que aún faltan muchas pruebas por hacerle al hongo y que es una muestra de la adaptación de las especies marinas; pues al ser proveniente de Asia, ha podido sobrevivir en otro hábitat distinto al suyo.